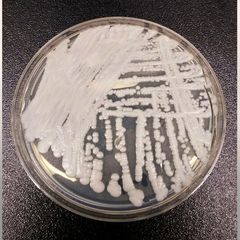

| |
Global Security Review at 9 a.m. EST Daily
Current Global Security News:
https://www.inoreader.com/stream/user/1006407045/tag/Security/view/html?cs=m&sb=y
Selected Articles Review From The News And Times -
https://thenewsandtimes.blogspot.com/
Current Selected Articles: https://www.inoreader.com/stream/user/1006407045/tag/user-favorites/view/html
All Current Articles: https://www.inoreader.com/stream/user/1006407045/tag/all-articles/view/html |
|
|
|
 | 1. World from Michael_Novakhov (27 sites): Radio Free Europe / Radio Liberty: The... |
| For more than a decade, Gulnara Karimova, the eldest daughter of Uzbekistan's first president, illegally... |
 Global Security News from Michael_Novakhov (30 sites) Global Security News from Michael_Novakhov (30 sites) | 2m | |
|
|
|
| How Finland's Armored Leopard 2 Mine-Clearing Tanks Differ From Germany's - Newsweek |
| How Finland's Armored Leopard 2 Mine-Clearing Tanks Differ From Germany's Newsweek |
 "Russia-Ukraine war" - Google News "Russia-Ukraine war" - Google News | 3m | |
|
|
|
| Erdoğan calls for 'immediate' end to war in Ukraine during call with Putin -... |
| Erdoğan calls for 'immediate' end to war in Ukraine during call with Putin Yahoo! Voices |
 "Russia-Ukraine war" - Google News "Russia-Ukraine war" - Google News | 3m | |
|
|
|
| EPA FY 2024 Budget Addresses TSCA, PFAS Senate Hearing - The National Law Review |
| EPA FY 2024 Budget Addresses TSCA, PFAS Senate Hearing The National Law Review |
 "global threats to U.S. security 2023" - Google News "global threats to U.S. security 2023" - Google News | 24m | |
|
|
|
| Mastercard Strengthens Customer Security With New AI 'Cyber Shield' - Yahoo Finance |
| Mastercard Strengthens Customer Security With New AI 'Cyber Shield' Yahoo Finance |
 "global threats to U.S. security" - Google News "global threats to U.S. security" - Google News | 30m | |
|
|
|
| 1. US Security from Michael_Novakhov (88 sites): "International Security"... |
| The view from Moscow and Beijing: What peace in Ukraine and a ... Kiowa County Press "International... |
 Global Security News from Michael_Novakhov (30 sites) Global Security News from Michael_Novakhov (30 sites) | 31m | |
|
|
|
| Helicopter Crashes In Iraqi Kurdistan Reminder That Peshmerga Lacks Basic Airpower... |
| Helicopter Crashes In Iraqi Kurdistan Reminder That Peshmerga Lacks Basic Airpower Forbes |
 "National security adviser Jake Sullivan" - Google News "National security adviser Jake Sullivan" - Google News | 32m | |
|
|
|
| Ukraine official: Putin taking Belarus as 'nuclear hostage' - The Pioneer |
| Ukraine official: Putin taking Belarus as 'nuclear hostage' The Pioneer |
 "National Security Council" - Google News "National Security Council" - Google News | 35m | |
|
|
|
| Top stories - Google News: How Florida uses a little-known law to punish abortion... |
| How Florida uses a little-known law to punish abortion clinics POLITICO Top stories - Google News |
 1. US Security from Michael_Novakhov (87 sites) 1. US Security from Michael_Novakhov (87 sites) | 52m | |
|
|
|
| Warning to Island drivers using these roads after diesel spill - Yahoo News UK |
| Warning to Island drivers using these roads after diesel spill Yahoo News UK |
 "russian fifth column" - Google News "russian fifth column" - Google News | 1h | |
|
|
|
| Demonstrators take a stand against gun violence at 'March For Our Lives' rally -... |
| Demonstrators take a stand against gun violence at 'March For Our Lives' rally KEYE TV CBS Austin |
 "Robb Elementary Uvalde" - Google News "Robb Elementary Uvalde" - Google News | 1h | |
|
|
|
| Can the South Korea–Japan rapprochement stick? - East Asia Forum |
| Can the South Korea–Japan rapprochement stick? East Asia Forum |
 "global threats to U.S. security" - Google News "global threats to U.S. security" - Google News | 1h | |
|
|
|
 | 1. Podcasts from Michael_Novakhov (21 sites): Voice of America - VOA Newscasts -... |
| Give us 5 minutes, and we'll give you the world. Around the clock, Voice of America keeps you in touch... |
 Global Security News from Michael_Novakhov (30 sites) Global Security News from Michael_Novakhov (30 sites) | 1h | |
|
|
|
 | The Global Security Review from Michael_Novakhov (13 sites): The Global Security... |
| The British Defense Ministry said on March 26 that Russia had "likely launched" at least 71 Iranian Shahed... |
 Global Security News from Michael_Novakhov (30 sites) Global Security News from Michael_Novakhov (30 sites) | 1h | |
|
|
|
 | |
| Michael Novakhov retweeted: MAGA House Republican proposals would slash... |
 Tweets by @mikenov Tweets by @mikenov | 1h | |
|
|
|
| |
| Selected Articles Review at 11 a.m. - Antony Blinken: "We meet at an inflection point. The post-Cold... |
 Tweets by @mikenov Tweets by @mikenov | 1h | |
|
|
|
| |
| Tweets Review at 5 p.m. https://t.co/yvLWEtb1TX https://t.co/E7lNbZVtNC Quoted tweet... |
 Tweets by @mikenov Tweets by @mikenov | 1h | |
|
|
|
| "Harold Thomas Martin" - Google News: Spring music preview 2023: A little... |
| Spring music preview 2023: A little bit of country and a little bit of ... Hartford Courant "Harold... |
 1. US Security from Michael_Novakhov (87 sites) 1. US Security from Michael_Novakhov (87 sites) | 1h | |
|
|
|
| "global security" - Google News: Sullivan: Granite State Democratic women... |
| Sullivan: Granite State Democratic women are history makers Foster's Daily Democrat "global security"... |
 1. US Security from Michael_Novakhov (87 sites) 1. US Security from Michael_Novakhov (87 sites) | 1h | |
|
|
|
| Russia accused of taking Belarus 'nuclear hostage' with deal to station missiles... |
| Russia accused of taking Belarus 'nuclear hostage' with deal to station missiles there The Guardian |
 "global threats to U.S. security" - Google News "global threats to U.S. security" - Google News | 1h | |
|
|
|
| Yes, it's crazy to have TikTok on official phones. But it's not good for any of us... |
| Yes, it's crazy to have TikTok on official phones. But it's not good for any of us The Guardian |
 "global threats to U.S. security" - Google News "global threats to U.S. security" - Google News | 1h | |
|
|
|
| Barboza sentenced in child's death - Uvalde Leader-News |
| Barboza sentenced in child's death Uvalde Leader-News |
 "Uvalde" - Google News "Uvalde" - Google News | 2h | |
|
|
|
 | The Washington Times stories: Security: Threat Status: U.S. flexing military muscle... |
| U.S. forces are set to engage in a massive showing of military force next month in East Asia, with Philippine... |
 1. US Security from Michael_Novakhov (87 sites) 1. US Security from Michael_Novakhov (87 sites) | 2h | |
|
|
|
| "International Security" - Google News: High rates of eczema could be caused... |
| High rates of eczema could be caused by the air that we breathe, new research suggests AOL "International... |
 1. US Security from Michael_Novakhov (87 sites) 1. US Security from Michael_Novakhov (87 sites) | 2h | |
|
|
|
| "International Security" - Google News: President Tsai delivers remarks... |
| President Tsai delivers remarks on the termination of diplomatic ... EIN News "International Security"... |
 1. US Security from Michael_Novakhov (87 sites) 1. US Security from Michael_Novakhov (87 sites) | 2h | |
|
|
|
| Russia's Bakhmut Offensive Hit With More Problems: U.K. - Newsweek |
| Russia's Bakhmut Offensive Hit With More Problems: U.K. Newsweek |
 "Russia-Ukraine war" - Google News "Russia-Ukraine war" - Google News | 2h | |
|
|
|
| Saucy Lady Lobos prepare for state competition - Uvalde Leader-News |
| Saucy Lady Lobos prepare for state competition Uvalde Leader-News |
 "Uvalde" - Google News "Uvalde" - Google News | 2h | |
|
|
|
| "Harold Thomas Martin" - Google News: Erie County real estate transactions... |
| Erie County real estate transactions Buffalo News "Harold Thomas Martin" - Google News |
 1. US Security from Michael_Novakhov (87 sites) 1. US Security from Michael_Novakhov (87 sites) | 2h | |
|
|
|
| "global security" - Google News: Interview: Xi's vision of community with... |
| Interview: Xi's vision of community with shared future represents ... China Daily "global security"... |
 1. US Security from Michael_Novakhov (87 sites) 1. US Security from Michael_Novakhov (87 sites) | 2h | |
|
|
|
| "Harold Thomas Martin" - Google News: Berks County real estate transactions... |
| Berks County real estate transactions for March 26 Reading Eagle "Harold Thomas Martin" - Google News |
 1. US Security from Michael_Novakhov (87 sites) 1. US Security from Michael_Novakhov (87 sites) | 2h | |
|
|
|
| Yes, it's crazy to have TikTok on official phones. But it's not good for ... - The... |
| Yes, it's crazy to have TikTok on official phones. But it's not good for ... The Guardian |
 "global threats to U.S. security" - Google News "global threats to U.S. security" - Google News | 2h | |
|
|
|
| Chinese netizens highlight contrast between treatments of Apple ... - Global Times |
| Chinese netizens highlight contrast between treatments of Apple ... Global Times |
 "global threats to U.S. security" - Google News "global threats to U.S. security" - Google News | 2h | |
|
|
|
| Joel O. Pérez - Uvalde Leader-News |
| Joel O. Pérez Uvalde Leader-News |
 "Uvalde" - Google News "Uvalde" - Google News | 3h | |
|
|
|
| Vietnam Veterans observance slated Wednesday - Uvalde Leader-News |
| Vietnam Veterans observance slated Wednesday Uvalde Leader-News |
 "Uvalde" - Google News "Uvalde" - Google News | 3h | |
|
|
|
| Educator remembered for talent - Uvalde Leader-News |
| Educator remembered for talent Uvalde Leader-News |
 "Uvalde" - Google News "Uvalde" - Google News | 3h | |
|
|
|
| Judge OKs UCISD's rehearing - Uvalde Leader-News |
| Judge OKs UCISD's rehearing Uvalde Leader-News |
 "Uvalde" - Google News "Uvalde" - Google News | 3h | |
|
|
|
| Utopia School moving to four-day format - Uvalde Leader-News |
| Utopia School moving to four-day format Uvalde Leader-News |
 "Uvalde" - Google News "Uvalde" - Google News | 3h | |
|
|
|
| Hundreds brave weather to honor Eva Mireles - Uvalde Leader-News |
| Hundreds brave weather to honor Eva Mireles Uvalde Leader-News |
 "Uvalde" - Google News "Uvalde" - Google News | 3h | |
|
|
|
| "us national security" - Google News: Asian Americans are anxious about... |
| Asian Americans are anxious about hate crimes. TikTok ban rhetoric isn't helping CNN "us national... |
 1. US Security from Michael_Novakhov (87 sites) 1. US Security from Michael_Novakhov (87 sites) | 3h | |
|
|
|
| "Harold Thomas Martin" - Google News: Berks County real estate transactions... |
| Berks County real estate transactions for March 26 Reading Eagle "Harold Thomas Martin" - Google News |
 1. US Security from Michael_Novakhov (87 sites) 1. US Security from Michael_Novakhov (87 sites) | 3h | |
|
|
|
| StrategyPage.com: WINNING: Improvising Around Sanctions |
| StrategyPage.com |
 1. US Security from Michael_Novakhov (87 sites) 1. US Security from Michael_Novakhov (87 sites) | 3h | |
|
|
|
| Preparations for 'de-occupation': Annexed Crimea not forgotten by Ukraine - CNN |
| Preparations for 'de-occupation': Annexed Crimea not forgotten by Ukraine CNN |
 "Russia-Ukraine war" - Google News "Russia-Ukraine war" - Google News | 3h | |
|
|
|
| An anxious Asia arms for a war it hopes to prevent - The Japan Times |
| An anxious Asia arms for a war it hopes to prevent The Japan Times |
 "global threats to U.S. security" - Google News "global threats to U.S. security" - Google News | 3h | |
|
|
|
| Report to Congress on Identification of, and Immigration Restrictions ... - Department... |
| Report to Congress on Identification of, and Immigration Restrictions ... Department of State |
 "global threats to U.S. security 2023" - Google News "global threats to U.S. security 2023" - Google News | 3h | |
|
|
|
 | 1. World from Michael_Novakhov (27 sites): BizToc: Burn Rate Paints Certain Pattern,... |
| Shiba Inu's (SHIB) burn rate has demonstrated a distinct pattern that may prove beneficial for traders... |
 Global Security News from Michael_Novakhov (30 sites) Global Security News from Michael_Novakhov (30 sites) | 3h | |
|
|
|
 | 1. World from Michael_Novakhov (27 sites): BizToc: Coinbase CEO Says Morale Soared... |
| As the crypto community responds with a mix of support and skepticism, the future of Coinbase hangs in... |
 Global Security News from Michael_Novakhov (30 sites) Global Security News from Michael_Novakhov (30 sites) | 3h | |
|
|
|
 | 1. World from Michael_Novakhov (27 sites): BizToc: Saudi Aramco Signs Deals with... |
| BizToc 1. World from Michael_Novakhov (27 sites) |
 Global Security News from Michael_Novakhov (30 sites) Global Security News from Michael_Novakhov (30 sites) | 3h | |
|
|
|
 | 1. World from Michael_Novakhov (27 sites): BizToc: S. Africa's Transnet Suspends... |
| BizToc 1. World from Michael_Novakhov (27 sites) |
 Global Security News from Michael_Novakhov (30 sites) Global Security News from Michael_Novakhov (30 sites) | 3h | |
|
|
|
 | 1. World from Michael_Novakhov (27 sites): BizToc: Tommy Flanagan's Sons Of Anarchy... |
| Tommy Flanagan's Sons Of Anarchy Stunts Left Him With Tons Of Aches And Pains The price of art is high,... |
 Global Security News from Michael_Novakhov (30 sites) Global Security News from Michael_Novakhov (30 sites) | 3h | |
|
|
|
 | 1. World from Michael_Novakhov (27 sites): BizToc: Key moments from Donald Trump's... |
| Donald Trump spoke at his first rally of his 2024 presidential campaign in Waco, Texas, on Saturday.... |
 Global Security News from Michael_Novakhov (30 sites) Global Security News from Michael_Novakhov (30 sites) | 3h | |
|
|
|
 | 1. World from Michael_Novakhov (27 sites): BizToc: Neiman Marcus Gets Luxury Exclusivity... |
| Nordstrom recently disappointed Wall Street when it announced a 4.1% decline in sales during its fourth... |
 Global Security News from Michael_Novakhov (30 sites) Global Security News from Michael_Novakhov (30 sites) | 3h | |
|
|
|
 | 1. World from Michael_Novakhov (27 sites): BizToc: A judge sided with publishers... |
| A judge sided with publishers in a lawsuit over the Internet Archive's online library A federal judge... |
 Global Security News from Michael_Novakhov (30 sites) Global Security News from Michael_Novakhov (30 sites) | 3h | |
|
|
|
| 1. World from Michael_Novakhov (27 sites): BizToc: 'A devastating impact': SVB's... |
| BizToc 1. World from Michael_Novakhov (27 sites) |
 Global Security News from Michael_Novakhov (30 sites) Global Security News from Michael_Novakhov (30 sites) | 3h | |
|
|
|
 | 1. World from Michael_Novakhov (27 sites): BizToc: Crypto prodigy, 23, is abducted... |
| A self-proclaimed Canadian 'crypto king' was allegedly kidnapped and tortured after he reportedly scammed... |
 Global Security News from Michael_Novakhov (30 sites) Global Security News from Michael_Novakhov (30 sites) | 3h | |
|
|
|
 | 1. World from Michael_Novakhov (27 sites): BizToc: Daily General Discussion and Advice... |
| BizToc 1. World from Michael_Novakhov (27 sites) |
 Global Security News from Michael_Novakhov (30 sites) Global Security News from Michael_Novakhov (30 sites) | 3h | |
|
|
|
 | 1. World from Michael_Novakhov (27 sites): BizToc: Giving employees flexibility works |
| This is the weekly Careers newsletter. Déjà Leonard is a copywriter and freelance journalist based in... |
 Global Security News from Michael_Novakhov (30 sites) Global Security News from Michael_Novakhov (30 sites) | 3h | |
|
|
|
 | 1. World from Michael_Novakhov (27 sites): BizToc: Esther Perel's Business Is Your... |
| Books, TED Talks and podcasts like "Where Should We Begin?" have made Esther Perel the world's best-known... |
 Global Security News from Michael_Novakhov (30 sites) Global Security News from Michael_Novakhov (30 sites) | 3h | |
|
|
|
 | 1. World from Michael_Novakhov (27 sites): BizToc: China opens ties with Honduras,... |
| BEIJING/TEGUCIGALPA/TAIPEI (Reuters) -China established diplomatic ties with Honduras on Sunday after... |
 Global Security News from Michael_Novakhov (30 sites) Global Security News from Michael_Novakhov (30 sites) | 3h | |
|
|
|
 | 1. World from Michael_Novakhov (27 sites): BizToc: Norway wealth fund to vote in... |
| Norway's $1.3 trillion sovereign wealth fund, one of the world's largest investors, will vote in favour... |
 Global Security News from Michael_Novakhov (30 sites) Global Security News from Michael_Novakhov (30 sites) | 3h | |
|
|
|
 | 1. World from Michael_Novakhov (27 sites): BizToc: Biden declares emergency for Mississippi... |
| Reuters. An aerial view of destroyed homes after thunderstorms spawning high straight-line winds and... |
 Global Security News from Michael_Novakhov (30 sites) Global Security News from Michael_Novakhov (30 sites) | 3h | |
|
|
|
 | 1. World from Michael_Novakhov (27 sites): BizToc: 'It's all about trolling': how... |
| He has a platform that most politicians would envy. But Jack Posobiec is not to be found on America's... |
 Global Security News from Michael_Novakhov (30 sites) Global Security News from Michael_Novakhov (30 sites) | 3h | |
|
|
|
 | 1. World from Michael_Novakhov (27 sites): BizToc: US mulls more support for banks... |
| U.S. authorities are considering the expansion of an emergency lending facility that would offer banks... |
 Global Security News from Michael_Novakhov (30 sites) Global Security News from Michael_Novakhov (30 sites) | 3h | |
|
|
|
 | 1. World from Michael_Novakhov (27 sites): BizToc: What's Going On at Deutsche Bank? |
| Deutsche Bank, Germany's largest lender, is one of 30 global systemically important banks that regulators... |
 Global Security News from Michael_Novakhov (30 sites) Global Security News from Michael_Novakhov (30 sites) | 3h | |
|
|
|
 | 1. World from Michael_Novakhov (27 sites): BizToc: Flashing 2020-Style Accumulation... |
| A closely followed trader believes that Bitcoin's (BTC) current market structure looks similar to its... |
 Global Security News from Michael_Novakhov (30 sites) Global Security News from Michael_Novakhov (30 sites) | 3h | |
|
|
|
| Iran-backed fighters put on alert - Arkansas Online |
| Iran-backed fighters put on alert Arkansas Online |
 "National Security Council" - Google News "National Security Council" - Google News | 3h | |
|
|
|
| Russia-Ukraine War turned quiet Rzeszów airport into a military hub - Business Insider |
| Russia-Ukraine War turned quiet Rzeszów airport into a military hub Business Insider |
 "russia-ukraine war" - Google News "russia-ukraine war" - Google News | 3h | |
|
|
|
| "global security" - Google News: An anxious Asia arms for a war it hopes... |
| An anxious Asia arms for a war it hopes to prevent Bangkok Post "global security" - Google News |
 1. US Security from Michael_Novakhov (87 sites) 1. US Security from Michael_Novakhov (87 sites) | 3h | |
|
|
|
| Putin says Moscow to station nuclear weapons in Belarus, Ukraine waits for more military... |
| Putin says Moscow to station nuclear weapons in Belarus, Ukraine waits for more military support from... |
 "Russia-Ukraine war" - Google News "Russia-Ukraine war" - Google News | 3h | |
|
|
|
| Ukraine war - live updates: US 'monitoring situation' after Putin 'signs ... - Sky... |
| Ukraine war - live updates: US 'monitoring situation' after Putin 'signs ... Sky News |
 "CIA Burns in Moscow" - Google News "CIA Burns in Moscow" - Google News | 3h | |
|
|
|
| Texas freight train deaths: Two people 'suffocate' and several are injured as police... |
| Texas freight train deaths: Two people 'suffocate' and several are injured as police receive unknown... |
 "Uvalde" - Google News "Uvalde" - Google News | 4h | |
|
|
|
| Top stories - Google News: Ryan Dorsey Reveals What 7-Year-Old Son Josey Knows About... |
| Ryan Dorsey Reveals What 7-Year-Old Son Josey Knows About His Late Mom Naya Rivera E! NEWSView Full... |
 1. US Security from Michael_Novakhov (87 sites) 1. US Security from Michael_Novakhov (87 sites) | 4h | |
|
|
|
| "Harold Thomas Martin" - Google News: Patricia Walstrom Obituary (1929... |
| Patricia Walstrom Obituary (1929 - 2023) Legacy.com "Harold Thomas Martin" - Google News |
 1. US Security from Michael_Novakhov (87 sites) 1. US Security from Michael_Novakhov (87 sites) | 4h | |
|
|
|
| "us national security" - Google News: Ukraine security chief says basing... |
| Ukraine security chief says basing Russian nuclear weapons in ... Reuters "us national security" -... |
 1. US Security from Michael_Novakhov (87 sites) 1. US Security from Michael_Novakhov (87 sites) | 4h | |
|
|
|
| Poland's secret war against Putin's spies – The First News - The First News |
| Poland's secret war against Putin's spies – The First News The First News |
 "russian spies in united states" - Google News "russian spies in united states" - Google News | 4h | |
|
|
|
| "International Security" - Google News: China brokered Saudi-Iran Peace... |
| China brokered Saudi-Iran Peace Deal has dented US image ummid.com "International Security" - Google... |
 1. US Security from Michael_Novakhov (87 sites) 1. US Security from Michael_Novakhov (87 sites) | 4h | |
|
|
|
| "International Security" - Google News: 'No more dollar diplomacy,' says... |
| 'No more dollar diplomacy,' says Tsai as Honduras cuts ties Focus Taiwan "International Security"... |
 1. US Security from Michael_Novakhov (87 sites) 1. US Security from Michael_Novakhov (87 sites) | 4h | |
|
|
|
| DPM Lawrence Wong at the 4th Singapore Defence Technology ... - Prime Minister's... |
| DPM Lawrence Wong at the 4th Singapore Defence Technology ... Prime Minister's Office Singapore |
 "global threats to U.S. security" - Google News "global threats to U.S. security" - Google News | 5h | |
|
|
|
| March 17, 2023 Russia-Ukraine news - CNN |
| March 17, 2023 Russia-Ukraine news CNN |
 "National Security Council" - Google News "National Security Council" - Google News | 5h | |
|
|
|
| "us national security" - Google News: Ebbing still has work before countries... |
| Ebbing still has work before countries can arrive in River Valley for ... Northwest Arkansas Democrat-Gazette... |
 1. US Security from Michael_Novakhov (87 sites) 1. US Security from Michael_Novakhov (87 sites) | 5h | |
|
|
|
| Russia Ukraine War | Upload Photos | telegraphherald.com - telegraphherald.com |
| Russia Ukraine War | Upload Photos | telegraphherald.com telegraphherald.com |
 "Russia-Ukraine war" - Google News "Russia-Ukraine war" - Google News | 5h | |
|
|
|
| Kia EV5 Concept Previews Smaller Electric SUV With More Swivel ... - The Drive |
| Kia EV5 Concept Previews Smaller Electric SUV With More Swivel ... The Drive |
 "global threats to U.S. security" - Google News "global threats to U.S. security" - Google News | 5h | |
|
|
|
| Russia pardons over 5,000 former criminals after fighting in Ukraine ... - Firstpost |
| Russia pardons over 5,000 former criminals after fighting in Ukraine ... Firstpost |
 "russian spies in united states" - Google News "russian spies in united states" - Google News | 6h | |
|
|
|
 | Vice Society claims attack on Puerto Rico Aqueduct and Sewer Authority |
| Puerto Rico Aqueduct and Sewer Authority (PRASA) is investigating a cyber attack with the help of the... |
 Security Affairs Security Affairs | 6h | |
|
|
|
| FBI from Michael_Novakhov (35 sites): NPR News Now: NPR News: 03-26-2023 2AM ET |
| NPR News: 03-26-2023 2AM ET ... |
 Global Security News from Michael_Novakhov (30 sites) Global Security News from Michael_Novakhov (30 sites) | 6h | |
|
|
|
| China opens ties with Honduras, Taiwan decries monetary demands - Reuters |
| China opens ties with Honduras, Taiwan decries monetary demands Reuters |
 "global threats to U.S. security 2023" - Google News "global threats to U.S. security 2023" - Google News | 6h | |
|
|
|
| Migrants found 'suffocating' in Texas train; 2 dead: police - FOX 29 Philadelphia |
| Migrants found 'suffocating' in Texas train; 2 dead: police FOX 29 Philadelphia |
 "Uvalde" - Google News "Uvalde" - Google News | 6h | |
|
|
|
| "house judiciary committee" - Google News: Alvin Bragg Rips House GOP Chairs... |
| Alvin Bragg Rips House GOP Chairs After Additional Inquiries Into Trump Case Yahoo News "house judiciary... |
 1. US Security from Michael_Novakhov (87 sites) 1. US Security from Michael_Novakhov (87 sites) | 6h | |
|
|
|
| "us national security" - Google News: Kishida vows to strengthen Japan's... |
| Kishida vows to strengthen Japan's defense capabilities over five ... The Japan Times "us national... |
 1. US Security from Michael_Novakhov (87 sites) 1. US Security from Michael_Novakhov (87 sites) | 6h | |
|
|
|
| "International Security" - Google News: Why is a better economy essential... |
| Why is a better economy essential for Nepal's national security in the ... Online Khabar (English) ... |
 1. US Security from Michael_Novakhov (87 sites) 1. US Security from Michael_Novakhov (87 sites) | 6h | |
|
|
|
| "Harold Thomas Martin" - Google News: 'Forever in our hearts': Heartfelt... |
| 'Forever in our hearts': Heartfelt tributes to loved ones in Gazette funeral and death notices Teesside... |
 1. US Security from Michael_Novakhov (87 sites) 1. US Security from Michael_Novakhov (87 sites) | 6h | |
|
|
|
| Russia-Ukraine war live: Kremlin has 'Belarus as nuclear hostage' with plans to station... |
| Russia-Ukraine war live: Kremlin has 'Belarus as nuclear hostage' with plans to station tactical nuclear... |
 "Russia-Ukraine war" - Google News "Russia-Ukraine war" - Google News | 6h | |
|
|
|
| Russia 'largely stalled' in Bakhmut, shifting focus, UK says - Yahoo! Voices |
| Russia 'largely stalled' in Bakhmut, shifting focus, UK says Yahoo! Voices |
 "Russia-Ukraine war" - Google News "Russia-Ukraine war" - Google News | 6h | |
|
|
|
| World Backup Day 2023: The Importance of Proactive Measures to ... - Spiceworks News... |
| World Backup Day 2023: The Importance of Proactive Measures to ... Spiceworks News and Insights |
 "global threats to U.S. security 2023" - Google News "global threats to U.S. security 2023" - Google News | 7h | |
|
|
|
| It means the world to him – Nathan Broadhead in tears after Wales goal on debut -... |
| It means the world to him – Nathan Broadhead in tears after Wales goal on debut AOL |
 "russian spies in united states" - Google News "russian spies in united states" - Google News | 7h | |
|
|
|
| Nathan Collins hopes to turn on style again as Republic of Ireland face France -... |
| Nathan Collins hopes to turn on style again as Republic of Ireland face France AOL |
 "russian spies in united states" - Google News "russian spies in united states" - Google News | 7h | |
|
|
|
| Jordan Pickford determined to be remembered as an England trophy winner - AOL |
| Jordan Pickford determined to be remembered as an England trophy winner AOL |
 "russian spies in united states" - Google News "russian spies in united states" - Google News | 7h | |
|
|
|
| Anthony Joshua: I'm among top heavyweights with Tyson Fury and Oleksandr Usyk - AOL |
| Anthony Joshua: I'm among top heavyweights with Tyson Fury and Oleksandr Usyk AOL |
 "russian spies in united states" - Google News "russian spies in united states" - Google News | 7h | |
|
|
|
 | |
| The commitment of conventional reserves could even prevent the attack from culminating and generate operationally... |
 ISW (Twitter) ISW (Twitter) | 7h | |
|
|
|
| |
| #Russian attacks in and around #Bakhmut may resume at high levels without generating significant new... |
 ISW (Twitter) ISW (Twitter) | 7h | |
|
|
|
| |
| #Russian forces may continue to attack #Bakhmut frequently and aggressively even if the offensive has... |
 ISW (Twitter) ISW (Twitter) | 7h | |
|
|
|
 | |
| #Ukrainian and Western officials offered various views of the state of the #Russian offensive in #Bakhmut... |
 ISW (Twitter) ISW (Twitter) | 7h | |
|
|
|
| "us national security" - Google News: Critical drug shortage a threat to... |
| Critical drug shortage a threat to national security, congressional report finds New York Post "us... |
 1. US Security from Michael_Novakhov (87 sites) 1. US Security from Michael_Novakhov (87 sites) | 7h | |
|
|
|
| Putin says Russia will station tactical nukes in Belarus - Spectrum News |
| Putin says Russia will station tactical nukes in Belarus Spectrum News |
 "National Security Council" - Google News "National Security Council" - Google News | 7h | |
|
|
|
| US and China wage war beneath the waves - over internet cables - CNA |
| US and China wage war beneath the waves - over internet cables CNA |
 "global threats to U.S. security" - Google News "global threats to U.S. security" - Google News | 7h | |
|
|
|
| Trump Investigations from Michael_Novakhov (126 sites): "Mueller's Russia i |
| Trump, facing potential indictment, holds defiant Waco rally MarketWatch "Mueller's Russia investigation"... |
 Global Security News from Michael_Novakhov (30 sites) Global Security News from Michael_Novakhov (30 sites) | 7h | |
|
|
|
| Cole visits Taiwan, Japan, South Korea - Journal Record |
| Cole visits Taiwan, Japan, South Korea Journal Record |
 "global threats to U.S. security 2023" - Google News "global threats to U.S. security 2023" - Google News | 7h | |
|
|
|
| From Balloons to Nukes, We Must Stop Inflating the China Threat - Defense One |
| From Balloons to Nukes, We Must Stop Inflating the China Threat Defense One |
 "global threats to U.S. security 2023" - Google News "global threats to U.S. security 2023" - Google News | 7h | |
|
|
|
| "Harold Thomas Martin" - Google News: Death notices in The Northern Echo... |
| Death notices in The Northern Echo between March 17 and March 24 The Northern Echo "Harold Thomas... |
 1. US Security from Michael_Novakhov (87 sites) 1. US Security from Michael_Novakhov (87 sites) | 7h | |
|
|
|
| Cameron Norrie crashes out in second round of Miami Open - AOL |
| Cameron Norrie crashes out in second round of Miami Open AOL |
 "russian spies in united states" - Google News "russian spies in united states" - Google News | 8h | |
|
|
|
| "International Security" - Google News: What peace in Ukraine and a post-conflict... |
| What peace in Ukraine and a post-conflict world look like to Xi and ... EastMojo "International Security"... |
 1. US Security from Michael_Novakhov (87 sites) 1. US Security from Michael_Novakhov (87 sites) | 8h | |
|
|
|
| |
| They do not reflect current #Russian realities or the balance of economic power or military industrial... |
 ISW (Twitter) ISW (Twitter) | 8h | |
|
|
|
| |
| ... to create the false impression that further #Ukrainian resistance & Western support to 🇺🇦is futile.... |
 ISW (Twitter) ISW (Twitter) | 8h | |
|
|
|
| |
| As #Russian offensives culminate and Ukraine prepares to launch counter-offensives, #Putin claimed that... |
 ISW (Twitter) ISW (Twitter) | 8h | |
|
|
|
 | |
| NEW: In an interview with a state-owned #Russian news channel on Mar. 25, President Vladimir #Putin launched... |
 ISW (Twitter) ISW (Twitter) | 8h | |
|
|
|
| U.S. intelligence leaders brief congress on global security threats - WFTV Orlando |
| U.S. intelligence leaders brief congress on global security threats WFTV Orlando |
 "global threats to U.S. security" - Google News "global threats to U.S. security" - Google News | 8h | |
|
|
|
| NASA Space Mission Takes Stock of Carbon Dioxide Emissions by ... - NASA Climate... |
| NASA Space Mission Takes Stock of Carbon Dioxide Emissions by ... NASA Climate Change |
 "global threats to U.S. security" - Google News "global threats to U.S. security" - Google News | 8h | |
|
|
|
| Ukraine says Bakhmut situation stabilising, Putin plays down tank shortage - South... |
| Ukraine says Bakhmut situation stabilising, Putin plays down tank shortage South China Morning Post |
 "russia-ukraine war" - Google News "russia-ukraine war" - Google News | 8h | |
|
|
|
 | Texans gather at Capitol for annual March for Our Lives - Jacksonville Daily Progress |
| Jacksonville Daily Progress |
 "Uvalde" - Google News "Uvalde" - Google News | 8h | |
|
|
|
| Putin says Moscow to station nuclear weapons in Belarus, Ukraine waits for more military... |
| Putin says Moscow to station nuclear weapons in Belarus, Ukraine waits for more military support from... |
 "Russia-Ukraine war" - Google News "Russia-Ukraine war" - Google News | 8h | |
|
|
|
| UN issues report condemning treatment of prisoners of war in ... - JURIST |
| UN issues report condemning treatment of prisoners of war in ... JURIST |
 "Russia-Ukraine war" - Google News "Russia-Ukraine war" - Google News | 8h | |
|
|
|
| "us national security" - Google News: US: No indication of Russia preparing... |
| US: No indication of Russia preparing to use nuclear weapon | NHK ... NHK WORLD "us national security"... |
 1. US Security from Michael_Novakhov (87 sites) 1. US Security from Michael_Novakhov (87 sites) | 9h | |
|
|
|
| Opening Remarks delivered by Adm. Stuart Munsch during AMFS - DVIDS |
| Opening Remarks delivered by Adm. Stuart Munsch during AMFS DVIDS |
 "global threats to U.S. security" - Google News "global threats to U.S. security" - Google News | 9h | |
|
|
|
| Trump Investigations from Michael_Novakhov (126 sites): "Trump Investigations"... |
| Manhattan DA, House GOP chairs ramp up battle over Trump ... POLITICO "Trump Investigations" - Google... |
 Global Security News from Michael_Novakhov (30 sites) Global Security News from Michael_Novakhov (30 sites) | 9h | |
|
|
|
| Poland breaks up Russian spy network, says minister - RTE.ie |
| Poland breaks up Russian spy network, says minister RTE.ie |
 "CIA Burns in Moscow" - Google News "CIA Burns in Moscow" - Google News | 9h | |
|
|
|
| Chinese communist way of war: Different than the West - Taiwan News |
| Chinese communist way of war: Different than the West Taiwan News |
 "russian spies in united states" - Google News "russian spies in united states" - Google News | 9h | |
|
|
|
| Should We Claim We Truly Understand International Politics? - Modern Diplomacy |
| Should We Claim We Truly Understand International Politics? Modern Diplomacy |
 "global threats to U.S. security" - Google News "global threats to U.S. security" - Google News | 9h | |
|
|
|
| UFC Fight Night: Vera vs Sandhagen Results | Winner Interviews ... - UFC |
| UFC Fight Night: Vera vs Sandhagen Results | Winner Interviews ... UFC |
 "russian fifth column" - Google News "russian fifth column" - Google News | 10h | |
|
|
|
| 1. World from Michael_Novakhov (27 sites): Deutsche Welle from Michael_Novakhov (6... |
| The Honduran government said that it is ending its diplomatic ties with Taiwan. Deutsche Welle Deutsche... |
 Global Security News from Michael_Novakhov (30 sites) Global Security News from Michael_Novakhov (30 sites) | 10h | |
|
|
|
| 1. World from Michael_Novakhov (27 sites): Deutsche Welle from Michael_Novakhov (6... |
| The Honduran government said that it is ending its diplomatic ties with Taiwan. Deutsche Welle: DW.com... |
 Global Security News from Michael_Novakhov (30 sites) Global Security News from Michael_Novakhov (30 sites) | 10h | |
|
|
|
 | 1. World from Michael_Novakhov (27 sites): Latest & Breaking News on Fox News: Trump... |
| Former President Donald Trump announced his campaign's Texas leadership team on Saturday night which... |
 Global Security News from Michael_Novakhov (30 sites) Global Security News from Michael_Novakhov (30 sites) | 10h | |
|
|
|
 | 1. World from Michael_Novakhov (27 sites): Latest & Breaking News on Fox News: France's... |
| Social media users were outraged by a recent clip of French President Emmanuel Macron appearing to hide... |
 Global Security News from Michael_Novakhov (30 sites) Global Security News from Michael_Novakhov (30 sites) | 10h | |
|
|
|
| "us national security" - Google News: It's time to amend the Espionage... |
| It's time to amend the Espionage Act The Hill "us national security" - Google News |
 1. US Security from Michael_Novakhov (87 sites) 1. US Security from Michael_Novakhov (87 sites) | 10h | |
|
|
|
| Trump Investigations from Michael_Novakhov (126 sites): "2016 Presidential Election... |
| '2024 is the final battle': Trump launches presidential campaign in ... KUT "2016 Presidential Election... |
 Global Security News from Michael_Novakhov (30 sites) Global Security News from Michael_Novakhov (30 sites) | 11h | |
|
|
|
| China, Russia and the Risk of a New Cold War - The New York Times |
| China, Russia and the Risk of a New Cold War The New York Times |
 "global threats to U.S. security 2023" - Google News "global threats to U.S. security 2023" - Google News | 11h | |
|
|
|
| Counter-Terrorism, March 2023 Monthly Forecast - Security Council Report |
| Counter-Terrorism, March 2023 Monthly Forecast Security Council Report |
 "global threats to U.S. security 2023" - Google News "global threats to U.S. security 2023" - Google News | 11h | |
|
|
|
| From rockets to ball bearings, Pentagon struggles to feed war machine - The Japan... |
| From rockets to ball bearings, Pentagon struggles to feed war machine The Japan Times |
 "global threats to U.S. security" - Google News "global threats to U.S. security" - Google News | 11h | |
|
|
|
| 1. Podcasts from Michael_Novakhov (21 sites): 1. NPR from Michael_Novakhov (25 sites):... |
| NPR News: 03-25-2023 9PM ET ... |
 Global Security News from Michael_Novakhov (30 sites) Global Security News from Michael_Novakhov (30 sites) | 11h | |
|
|
|
| Firefighters extinguish fire in Home Depot HVAC unit on roof - Yahoo News |
| Firefighters extinguish fire in Home Depot HVAC unit on roof Yahoo News |
 "russian fifth column" - Google News "russian fifth column" - Google News | 11h | |
|
|
|
| "International Security" - Google News: No good would come out of AUKUS... |
| No good would come out of AUKUS China Economic Net "International Security" - Google News |
 1. US Security from Michael_Novakhov (87 sites) 1. US Security from Michael_Novakhov (87 sites) | 11h | |
|
|
|
 | Saved Web Pages - Daily Report at 9 p.m. |
| ... |
 The News And Times The News And Times | 12h | |
|
|
|
| Russia pardons 5,000 former criminals after fighting in Ukraine, Prigozhin says -... |
| Russia pardons 5,000 former criminals after fighting in Ukraine, Prigozhin says Yahoo News |
 "russian spies in united states" - Google News "russian spies in united states" - Google News | 12h | |
|
|
|
| Biden, Trudeau mount show of unity as allies paper over tensions - The Spokesman... |
| Biden, Trudeau mount show of unity as allies paper over tensions The Spokesman Review |
 "National security adviser Jake Sullivan" - Google News "National security adviser Jake Sullivan" - Google News | 12h | |
|
|
|
| Kamala Harris Africa trip: Can US charm offensive woo continent from China? - BBC |
| Kamala Harris Africa trip: Can US charm offensive woo continent from China? BBC |
 "Blinken: US to lead international Russia-Ukraine bloc against China" - Google News "Blinken: US to lead international Russia-Ukraine bloc against China" - Google News | 12h | |
|
|
|
| At least 17 people rescued from train car in Uvalde, Texas - Yahoo! Voices |
| At least 17 people rescued from train car in Uvalde, Texas Yahoo! Voices |
 "Uvalde" - Google News "Uvalde" - Google News | 12h | |
|
|
|
| Hotel Rwanda hero Paul Rusesabagina freed from prison - FOX 29 |
| Hotel Rwanda hero Paul Rusesabagina freed from prison FOX 29 |
 "National security adviser Jake Sullivan" - Google News "National security adviser Jake Sullivan" - Google News | 12h | |
|
|
|
| "house judiciary committee" - Google News: GOP weighs protecting Trump... |
| GOP weighs protecting Trump with law shielding ex-presidents from prosecution Yahoo News "house judiciary... |
 1. US Security from Michael_Novakhov (87 sites) 1. US Security from Michael_Novakhov (87 sites) | 12h | |
|
|
|
| "us national security" - Google News: It's time to amend the Espionage... |
| It's time to amend the Espionage Act The Hill "us national security" - Google News |
 1. US Security from Michael_Novakhov (87 sites) 1. US Security from Michael_Novakhov (87 sites) | 12h | |
|
|
|
| A Refuge for Russians and Ukrainians, Bali Rethinks Its Open-Door Policy - The New... |
| A Refuge for Russians and Ukrainians, Bali Rethinks Its Open-Door Policy The New York Times |
 "russia-ukraine war" - Google News "russia-ukraine war" - Google News | 12h | |
|
|
|
| A closer look at MP Han Dong's voting record on China - Global News |
| A closer look at MP Han Dong's voting record on China Global News |
 "global threats to U.S. security" - Google News "global threats to U.S. security" - Google News | 12h | |
|
|
|
| Uvalde, TX mayor tells Biden to 'face reality' after suspected smuggling attempt... |
| Uvalde, TX mayor tells Biden to 'face reality' after suspected smuggling attempt leaves two migrants... |
 "Uvalde" - Google News "Uvalde" - Google News | 12h | |
|
|
|
| Gareth Southgate has no issue with Marcus Rashford's trip to New York - AOL |
| Gareth Southgate has no issue with Marcus Rashford's trip to New York AOL |
 "russian spies in united states" - Google News "russian spies in united states" - Google News | 13h | |
|
|
|
| Effects of Russia-Ukraine War Felt at Miami Open - InsideHook |
| Effects of Russia-Ukraine War Felt at Miami Open InsideHook |
 "Russia-Ukraine war" - Google News "Russia-Ukraine war" - Google News | 13h | |
|
|
|
| Nurses use an extraordinary trick on Russians to save children - CNN |
| Nurses use an extraordinary trick on Russians to save children CNN |
 "russia-ukraine war" - Google News "russia-ukraine war" - Google News | 13h | |
|
|
|
| Video At least 17 people rescued from train car in Uvalde, Texas - ABC News |
| Video At least 17 people rescued from train car in Uvalde, Texas ABC News |
 "Uvalde" - Google News "Uvalde" - Google News | 13h | |
|
|
|
| Two migrants suffocate to death aboard Texas train, 10 hospitalized - msnNOW |
| Two migrants suffocate to death aboard Texas train, 10 hospitalized msnNOW |
 "Uvalde" - Google News "Uvalde" - Google News | 13h | |
|
|
|
| Texas police: Migrants found 'suffocating' in train; 2 dead - TheGrio |
| Texas police: Migrants found 'suffocating' in train; 2 dead TheGrio |
 "Uvalde" - Google News "Uvalde" - Google News | 13h | |
|
|
|
| Security Boulevard: Linking Lit's Lightweight Web Components And WebR For Vanilla... |
| See it live before reading! This is a Lit + WebR reproduction of the OG Shiny Demo App Lit is a javascript... |
 1. US Security from Michael_Novakhov (87 sites) 1. US Security from Michael_Novakhov (87 sites) | 13h | |
|
|
|
| Harris heads to Africa amid Biden's courtship of continent - The Spokesman Review |
| Harris heads to Africa amid Biden's courtship of continent The Spokesman Review |
 "Blinken: US to lead international Russia-Ukraine bloc against China" - Google News "Blinken: US to lead international Russia-Ukraine bloc against China" - Google News | 13h | |
|
|
|
 | |
| Here are today's control-of-terrain maps of #Russia's invasion of #Ukraine from @TheStudyofWar and @criticalthreats.... |
 ISW (Twitter) ISW (Twitter) | 13h | |
|
|
|
| New details on migrants found in train near Uvalde - KENS5.com |
| New details on migrants found in train near Uvalde KENS5.com |
 "Uvalde" - Google News "Uvalde" - Google News | 14h | |
|
|
|
| 2 dead in rail car near Uvalde; human smuggling investigation indicated - KSAT San... |
| 2 dead in rail car near Uvalde; human smuggling investigation indicated KSAT San Antonio |
 "Uvalde" - Google News "Uvalde" - Google News | 14h | |
|
|
|
| Uvalde, TX Mayor Don McLaughlin sounds off on border crisis: 'How many lives have... |
| Uvalde, TX Mayor Don McLaughlin sounds off on border crisis: 'How many lives have to be lost?' Fox News |
 "Uvalde" - Google News "Uvalde" - Google News | 14h | |
|
|
|
 | Trump Investigations from Michael_Novakhov (126 sites): Trump News TV from Michael_Novakhov... |
| ... |
 Global Security News from Michael_Novakhov (30 sites) Global Security News from Michael_Novakhov (30 sites) | 14h | |
|
|
|
 | Trump Investigations from Michael_Novakhov (126 sites): Trump News TV from Michael_Novakhov... |
| ... |
 Global Security News from Michael_Novakhov (30 sites) Global Security News from Michael_Novakhov (30 sites) | 14h | |
|
|
|
| Russia pardons 5,000 former criminals after fighting in Ukraine, Prigozhin says -... |
| Russia pardons 5,000 former criminals after fighting in Ukraine, Prigozhin says Devdiscourse |
 "russian spies in united states" - Google News "russian spies in united states" - Google News | 14h | |
|
|
|
| "global security" - Google News: Axis Communications Launches "Connect"... |
| Axis Communications Launches "Connect" Podcast Aimed at ... Wire19 "global security" - Google News |
 1. US Security from Michael_Novakhov (87 sites) 1. US Security from Michael_Novakhov (87 sites) | 14h | |
|
|
|
| Foreign Correspondent reporter Stephanie March on the challenges and heartbreak of... |
| Foreign Correspondent reporter Stephanie March on the challenges and heartbreak of filming a story about... |
 "global threats to U.S. security 2023" - Google News "global threats to U.S. security 2023" - Google News | 14h | |
|
|
|
| Sliding Toward a New Cold War - The New Yorker |
| Sliding Toward a New Cold War The New Yorker |
 "global threats to U.S. security 2023" - Google News "global threats to U.S. security 2023" - Google News | 14h | |
|
|
|
| Two migrants found dead in shipping container on train in Uvalde County, Texas -... |
| Two migrants found dead in shipping container on train in Uvalde County, Texas Channel3000.com - WISC-TV3 |
 "Uvalde" - Google News "Uvalde" - Google News | 15h | |
|
|
|
| Ukraine war: UK defends sending depleted uranium shells after ... - BBC |
| Ukraine war: UK defends sending depleted uranium shells after ... BBC |
 "russia-ukraine war" - Google News "russia-ukraine war" - Google News | 15h | |
|
|
|
| 1. World from Michael_Novakhov (27 sites): Voice of America: VOA 1 - The Hits |
| VOA1 is the Voice of America's 24/7 English language music network. Hear the freshest cuts from chart-toppers... |
 Global Security News from Michael_Novakhov (30 sites) Global Security News from Michael_Novakhov (30 sites) | 15h | |
|
|
|
 | 1. World from Michael_Novakhov (27 sites): Voice of America: VOA Newscasts |
| Give us 5 minutes, and we'll give you the world. Around the clock, Voice of America keeps you in touch... |
 Global Security News from Michael_Novakhov (30 sites) Global Security News from Michael_Novakhov (30 sites) | 15h | |
|
|
|
| 1. World from Michael_Novakhov (27 sites): Voice of America: VOA Newscasts |
| Give us 5 minutes, and we'll give you the world. Around the clock, Voice of America keeps you in touch... |
 Global Security News from Michael_Novakhov (30 sites) Global Security News from Michael_Novakhov (30 sites) | 15h | |
|
|
|
 | NCA infiltrates the cybercriminal underground with fake DDoS-for-hire sites |
| The U.K. National Crime Agency (NCA) revealed that it has set up a number of fake DDoS-for-hire sites... |
 Security Affairs Security Affairs | 15h | |
|
|
|
| TribCast: Police officers' fear of the AR-15 in Robb Elementary - Gilmer Mirror |
| TribCast: Police officers' fear of the AR-15 in Robb Elementary Gilmer Mirror |
 "Robb Elementary Uvalde" - Google News "Robb Elementary Uvalde" - Google News | 15h | |
|
|
|
| Two migrants found dead in shipping container on train in Uvalde County, Texas -... |
| Two migrants found dead in shipping container on train in Uvalde County, Texas WGAL Susquehanna Valley... |
 "Uvalde" - Google News "Uvalde" - Google News | 15h | |
|
|
|
| A Year Into War, Ukraine Faces Challenges Mobilizing Troops - The Wall Street Journal |
| A Year Into War, Ukraine Faces Challenges Mobilizing Troops The Wall Street Journal |
 "Russia-Ukraine war" - Google News "Russia-Ukraine war" - Google News | 15h | |
|
|
|
| "International Security" - Google News: IAEA Director General Grossi Travels... |
| IAEA Director General Grossi Travels to Zaporizhzhya Nuclear ... International Atomic Energy Agency... |
 1. US Security from Michael_Novakhov (87 sites) 1. US Security from Michael_Novakhov (87 sites) | 15h | |
|
|
|
| FBI from Michael_Novakhov (35 sites): "fbi surveillance" - Google News:... |
| B&B Recap: Sheila Thinks Bill's Proposal is Too Good to be True Daytime Confidential "fbi surveillance"... |
 Global Security News from Michael_Novakhov (30 sites) Global Security News from Michael_Novakhov (30 sites) | 15h | |
|
|
|
 | Tweets Review at 5 p.m. |
| ... |
 The News And Times The News And Times | 16h | |
|
|
|
| Russia-Ukraine war: Vladimir Putin to deploy nuclear weapons in ... - The Australian... |
| Russia-Ukraine war: Vladimir Putin to deploy nuclear weapons in ... The Australian Financial Review |
 "Russia-Ukraine war" - Google News "Russia-Ukraine war" - Google News | 16h | |
|
|
|
| "us national security" - Google News: Alexandria Ocasio-Cortez Goes on... |
| Alexandria Ocasio-Cortez Goes on TikTok to Argue Against a Ban The New York Times "us national security"... |
 1. US Security from Michael_Novakhov (87 sites) 1. US Security from Michael_Novakhov (87 sites) | 16h | |
|
|
|
| Man arrested after allegedly trying to open emergency door on plane and stabbing... |
| Man arrested after allegedly trying to open emergency door on plane and stabbing flight attendant CNN |
 "global threats to U.S. security 2023" - Google News "global threats to U.S. security 2023" - Google News | 16h | |
|
|
|
 | 1. World from Michael_Novakhov (27 sites): Voice of America: Spiking Violence Strains... |
| Hussein Maytham and his family were driving past the palm tree grove near their home after shopping for... |
 Global Security News from Michael_Novakhov (30 sites) Global Security News from Michael_Novakhov (30 sites) | 16h | |
|
|
|
| 1. Russia from Michael_Novakhov (114 sites): "US military options in Syria"... |
| Iran-Iraq agreement about more than borders Al-Monitor "US military options in Syria" - Google News... |
 Global Security News from Michael_Novakhov (30 sites) Global Security News from Michael_Novakhov (30 sites) | 16h | |
|
|
|
 | 1. World from Michael_Novakhov (27 sites): Voice of America: VOA Newscasts |
| Give us 5 minutes, and we'll give you the world. Around the clock, Voice of America keeps you in touch... |
 Global Security News from Michael_Novakhov (30 sites) Global Security News from Michael_Novakhov (30 sites) | 16h | |
|
|
|
| 2 dead in rail car; human smuggling investigation indicated - Spectrum News NY1 |
| 2 dead in rail car; human smuggling investigation indicated Spectrum News NY1 |
 "Robb Elementary Uvalde" - Google News "Robb Elementary Uvalde" - Google News | 16h | |
|
|
|
| International court issues war crimes warrant for Putin - The Reporter |
| International court issues war crimes warrant for Putin The Reporter |
 "National Security Council" - Google News "National Security Council" - Google News | 16h | |
|
|
|
| Biden, Trudeau mount show of unity as allies paper over tensions - Brunswick News |
| Biden, Trudeau mount show of unity as allies paper over tensions Brunswick News |
 "National security adviser Jake Sullivan" - Google News "National security adviser Jake Sullivan" - Google News | 16h | |
|
|
|
| "global security" - Google News: The clean energy transition needs an era... |
| The clean energy transition needs an era of industrial statesmanship The Hill "global security" -... |
 1. US Security from Michael_Novakhov (87 sites) 1. US Security from Michael_Novakhov (87 sites) | 16h | |
|
|
|
| 2 dead in rail car; human smuggling investigation indicated - Torrington Register... |
| 2 dead in rail car; human smuggling investigation indicated Torrington Register Citizen |
 "Uvalde" - Google News "Uvalde" - Google News | 17h | |
|
|
|
| Texas authorities say at least 2 migrants dead, over a dozen injured after 'suffocating'... |
| Texas authorities say at least 2 migrants dead, over a dozen injured after 'suffocating' in train car Fox... |
 "Uvalde" - Google News "Uvalde" - Google News | 17h | |
|
|
|
| International court issues war crimes warrant for Putin - The Delaware County Daily... |
| International court issues war crimes warrant for Putin The Delaware County Daily Times |
 "National Security Council" - Google News "National Security Council" - Google News | 17h | |
|
|
|
| "house judiciary committee" - Google News: 'Stop Calling Us With This Bulls**t':... |
| 'Stop Calling Us With This Bulls**t': Manhattan DA Bragg's Office Insults, Hangs Up On Judiciary Committee... |
 1. US Security from Michael_Novakhov (87 sites) 1. US Security from Michael_Novakhov (87 sites) | 17h | |
|
|
|
| "house judiciary committee" - Google News: House GOP vows on 'following... |
| House GOP vows on 'following through' with vote on major change to Constitution: 'Great response' Fox... |
 1. US Security from Michael_Novakhov (87 sites) 1. US Security from Michael_Novakhov (87 sites) | 17h | |
|
|
|
| Putin says Russia to place tactical nuclear arms in Belarus - Oil City Derrick |
| Putin says Russia to place tactical nuclear arms in Belarus Oil City Derrick |
 "russian fifth column" - Google News "russian fifth column" - Google News | 17h | |
|
|
|
| Putin says Russia will station tactical nukes in Belarus - Oil City Derrick |
| Putin says Russia will station tactical nukes in Belarus Oil City Derrick |
 "russian fifth column" - Google News "russian fifth column" - Google News | 17h | |
|
|
|
| To counter the Wagner Group's presence in Africa, the US will need ... - Atlantic... |
| To counter the Wagner Group's presence in Africa, the US will need ... Atlantic Council |
 "global threats to U.S. security 2023" - Google News "global threats to U.S. security 2023" - Google News | 17h | |
|
|
|
| Putin: will 'take into account' NATO's nuclear capability - KEYE TV CBS Austin |
| Putin: will 'take into account' NATO's nuclear capability KEYE TV CBS Austin |
 "CIA Burns in Moscow" - Google News "CIA Burns in Moscow" - Google News | 17h | |
|
|
|
| Two dead among numerous people found 'suffocating' in train car in ... - WVTF |
| Two dead among numerous people found 'suffocating' in train car in ... WVTF |
 "Robb Elementary Uvalde" - Google News "Robb Elementary Uvalde" - Google News | 17h | |
|
|
|
| 2 dead in rail car; human smuggling investigation indicated - Jacksonville Journal-Courier |
| 2 dead in rail car; human smuggling investigation indicated Jacksonville Journal-Courier |
 "Uvalde" - Google News "Uvalde" - Google News | 17h | |
|
|
|
| "us national security" - Google News: 'We are not China': TikTok boss says... |
| 'We are not China': TikTok boss says the app is not a national security threat Sydney Morning Herald... |
 1. US Security from Michael_Novakhov (87 sites) 1. US Security from Michael_Novakhov (87 sites) | 17h | |
|
|
|
| Migrants in Deadly Texas Incident Were Locked in Train Car for Hours: Mayor - msnNOW |
| Migrants in Deadly Texas Incident Were Locked in Train Car for Hours: Mayor msnNOW |
 "Uvalde" - Google News "Uvalde" - Google News | 18h | |
|
|
|
| "International Security" - Google News: Looking at the Ukraine conflict... |
| Looking at the Ukraine conflict through the eyes of Russia and China Scroll.in "International Security"... |
 1. US Security from Michael_Novakhov (87 sites) 1. US Security from Michael_Novakhov (87 sites) | 18h | |
|
|
|
| Ottawa International Airport, InDro, provide drone detection during ... - sUAS News |
| Ottawa International Airport, InDro, provide drone detection during ... sUAS News |
 "global threats to U.S. security" - Google News "global threats to U.S. security" - Google News | 18h | |
|
|
|
| Maritime Security & Geopolitics in Indian Ocean Region - Modern Diplomacy |
| Maritime Security & Geopolitics in Indian Ocean Region Modern Diplomacy |
 "global threats to U.S. security" - Google News "global threats to U.S. security" - Google News | 18h | |
|
|
|
| Russia 'largely stalled' in Bakhmut, shifting focus, U.K. says - Press Herald |
| Russia 'largely stalled' in Bakhmut, shifting focus, U.K. says Press Herald |
 "Russia-Ukraine war" - Google News "Russia-Ukraine war" - Google News | 18h | |
|
|
|
 | |
| ISW retweeted: The news of a Russian nuclear weapons deployment to Belarus... |
 ISW (Twitter) ISW (Twitter) | 18h | |
|
|
|
| "global security" - Google News: Build community with shared future, create... |
| Build community with shared future, create better world PR Newswire "global security" - Google News |
 1. US Security from Michael_Novakhov (87 sites) 1. US Security from Michael_Novakhov (87 sites) | 18h | |
|
|
|
| Biden, Trudeau mount show of unity as allies paper over tensions - Walla Walla Union-Bulletin |
| Biden, Trudeau mount show of unity as allies paper over tensions Walla Walla Union-Bulletin |
 "National security adviser Jake Sullivan" - Google News "National security adviser Jake Sullivan" - Google News | 18h | |
|
|
|
| 1. Russia from Michael_Novakhov (114 sites): "путин" - Google Новости:... |
| США заявили о новом оружии во время визита лидера КНР ... ИА Красная Весна "путин" - Google Новости... |
 Global Security News from Michael_Novakhov (30 sites) Global Security News from Michael_Novakhov (30 sites) | 18h | |
|
|
|
| 1. Russia from Michael_Novakhov (114 sites): "путин" - Google Новости:... |
| Путин заявил о размещении в Белоруссии 10 самолетов, способных нести тактическое ядерное оружие Интерфакс... |
 Global Security News from Michael_Novakhov (30 sites) Global Security News from Michael_Novakhov (30 sites) | 18h | |
|
|
|
| 1. Russia from Michael_Novakhov (114 sites): "путин" - Google Новости:... |
| Путин заявил о строительстве хранилища для тактического ... The Insider "путин" - Google Новости ... |
 Global Security News from Michael_Novakhov (30 sites) Global Security News from Michael_Novakhov (30 sites) | 18h | |
|
|
|
| 1. Russia from Michael_Novakhov (114 sites): "путин" - Google Новости:... |
| Путин: Россия летом закончит строительство в Белоруссии ... Фонтанка.Ру "путин" - Google Новости ... |
 Global Security News from Michael_Novakhov (30 sites) Global Security News from Michael_Novakhov (30 sites) | 18h | |
|
|
|
 | 1. World from Michael_Novakhov (27 sites): CNN.com - RSS Channel - World: Daylight... |
| Already facing one of the world's worst economic crises, the Lebanese people could soon face a new challenge... |
 Global Security News from Michael_Novakhov (30 sites) Global Security News from Michael_Novakhov (30 sites) | 18h | |
|
|
|
| Ukraine war throws wrench in massive Russian arms deal after they ... - msnNOW |
| Ukraine war throws wrench in massive Russian arms deal after they ... msnNOW |
 "russian spies in united states" - Google News "russian spies in united states" - Google News | 19h | |
|
|
|
| Texas police: Migrants found 'suffocating' in train; 2 dead - Kennebec Journal and... |
| Texas police: Migrants found 'suffocating' in train; 2 dead Kennebec Journal and Morning Sentinel |
 "Uvalde" - Google News "Uvalde" - Google News | 19h | |
|
|
|
| Russia Calls for U.N. Investigation of Nord Stream Attack - The Intercept |
| Russia Calls for U.N. Investigation of Nord Stream Attack The Intercept |
 "National Security Council" - Google News "National Security Council" - Google News | 19h | |
|
|
|
| Tsai reviews troops ahead of sensitive visit to the US - 台北時報 |
| Tsai reviews troops ahead of sensitive visit to the US 台北時報 |
 "National Security Council" - Google News "National Security Council" - Google News | 19h | |
|
|
|
| "Harold Thomas Martin" - Google News: On this Date - Aerotech News |
| On this Date Aerotech News "Harold Thomas Martin" - Google News |
 1. US Security from Michael_Novakhov (87 sites) 1. US Security from Michael_Novakhov (87 sites) | 19h | |
|
|
|
| EDITORIAL: Anti-war group noble but misguided - 台北時報 |
| EDITORIAL: Anti-war group noble but misguided 台北時報 |
 "global threats to U.S. security 2023" - Google News "global threats to U.S. security 2023" - Google News | 19h | |
|
|
|
| Stolen Valor: The U.S. Volunteers in Ukraine Who Lie, Waste and Bicker - The New... |
| Stolen Valor: The U.S. Volunteers in Ukraine Who Lie, Waste and Bicker The New York Times |
 "russia-ukraine war" - Google News "russia-ukraine war" - Google News | 19h | |
|
|
|
| Ukraine War: Why has Russia's assault on Bakhmut stalled? - Sky News |
| Ukraine War: Why has Russia's assault on Bakhmut stalled? Sky News |
 "russia-ukraine war" - Google News "russia-ukraine war" - Google News | 19h | |
|
|
|
| Security Boulevard: USENIX Security '22 – Xudong Pan, Mi Zhang, Beina Sheng, Jiaming... |
| Our thanks to USENIX for publishing their Presenter's outstanding USENIX Security '22 Conference content... |
 1. US Security from Michael_Novakhov (87 sites) 1. US Security from Michael_Novakhov (87 sites) | 19h | |
|
|
|
| Bali governor puts Indonesia on the spot - Modern Diplomacy |
| Bali governor puts Indonesia on the spot Modern Diplomacy |
 "global threats to U.S. security" - Google News "global threats to U.S. security" - Google News | 19h | |
|
|
|
| Takeaways From The State Department's Report On Terrorism - Critical Threats Project |
| Takeaways From The State Department's Report On Terrorism Critical Threats Project |
 "global threats to U.S. security 2023" - Google News "global threats to U.S. security 2023" - Google News | 19h | |
|
|
|
| Russia pardons over 5,000 former criminals after fighting in Ukraine, says Wagner... |
| Russia pardons over 5,000 former criminals after fighting in Ukraine, says Wagner Group founder Firstpost |
 "russian spies in united states" - Google News "russian spies in united states" - Google News | 19h | |
|
|
|
| "global security" - Google News: Xinhua Commentary: No good would come... |
| Xinhua Commentary: No good would come out of AUKUS Xinhua "global security" - Google News |
 1. US Security from Michael_Novakhov (87 sites) 1. US Security from Michael_Novakhov (87 sites) | 20h | |
|
|
|
| "global security" - Google News: Build community with shared future, create... |
| Build community with shared future, create better world Yahoo Canada Finance "global security" - Google... |
 1. US Security from Michael_Novakhov (87 sites) 1. US Security from Michael_Novakhov (87 sites) | 20h | |
|
|
|
| Top stories - Google News: U.S. will 'act forcefully' to protect Americans, Biden... |
| U.S. will 'act forcefully' to protect Americans, Biden warns Iran after clashes in Syria NBC NewsTwo... |
 1. US Security from Michael_Novakhov (87 sites) 1. US Security from Michael_Novakhov (87 sites) | 20h | |
|
|
|
 | Pwn2Own Vancouver 2023 awarded $1,035,000 and a Tesla for 27 0-days |
| On the third day of the Pwn2Own Vancouver 2023 hacking contest, the organization awarded $185,000 for... |
 Security Affairs Security Affairs | 20h | |
|
|
|
| Russia-Ukraine war collapsing poultry industry in Bono Region ... - GhanaWeb |
| Russia-Ukraine war collapsing poultry industry in Bono Region ... GhanaWeb |
 "russia-ukraine war" - Google News "russia-ukraine war" - Google News | 20h | |
|
|
|
| Texas police: Migrants found 'suffocating' in train; 2 dead - Sent-trib - Sentinel-Tribune |
| Texas police: Migrants found 'suffocating' in train; 2 dead - Sent-trib Sentinel-Tribune |
 "Uvalde" - Google News "Uvalde" - Google News | 20h | |
|
|
|
| Ukraine says battle for Bakhmut is 'stabilizing' - Yahoo News |
| Ukraine says battle for Bakhmut is 'stabilizing' Yahoo News |
 "russia-ukraine war" - Google News "russia-ukraine war" - Google News | 21h | |
|
|
|
| UPDATE 3-China watching world's response to Ukraine war, has not crossed lethal aid... |
| UPDATE 3-China watching world's response to Ukraine war, has not crossed lethal aid line -Blinken Yahoo... |
 "Blinken: US to lead international Russia-Ukraine bloc against China" - Google News "Blinken: US to lead international Russia-Ukraine bloc against China" - Google News | 21h | |
|
|
|
| "us national security" - Google News: 3/25/23 National Security and Korean... |
| 3/25/23 National Security and Korean News and Commentary smallwarsjournal "us national security" -... |
 1. US Security from Michael_Novakhov (87 sites) 1. US Security from Michael_Novakhov (87 sites) | 21h | |
|
|
|
| Top stories - Google News: See moment Pennsylvania candy factory explodes - CNN |
| See moment Pennsylvania candy factory explodes CNNExplosion at R.M. Palmer chocolate factory in Pennsylvania... |
 1. US Security from Michael_Novakhov (87 sites) 1. US Security from Michael_Novakhov (87 sites) | 21h | |
|
|
|
| Why TikTok is so hard to ban in the US, according to experts - Fox News |
| Why TikTok is so hard to ban in the US, according to experts Fox News |
 "National security adviser Jake Sullivan" - Google News "National security adviser Jake Sullivan" - Google News | 21h | |
|
|
|
| 1. Russia from Michael_Novakhov (114 sites): "russia france" - Google News:... |
| Russia pardons over 5,000 convicts after fighting in Ukraine with Wagner Group FRANCE 24 English "russia... |
 Global Security News from Michael_Novakhov (30 sites) Global Security News from Michael_Novakhov (30 sites) | 21h | |
|
|
|
| Migrants found "suffocating" inside train car, 2 killed - Axios |
| Migrants found "suffocating" inside train car, 2 killed Axios |
 "Uvalde" - Google News "Uvalde" - Google News | 21h | |
|
|
|
| Two migrants found dead in shipping container on train in Uvalde County, Texas -... |
| Two migrants found dead in shipping container on train in Uvalde County, Texas CNN |
 "Uvalde" - Google News "Uvalde" - Google News | 21h | |
|
|
|
| Texas police: Migrants found 'suffocating' in train; 2 dead - mykxlg.com |
| Texas police: Migrants found 'suffocating' in train; 2 dead mykxlg.com |
 "Uvalde" - Google News "Uvalde" - Google News | 21h | |
|
|
|
 | Selected Articles Review at 11 a.m. - Antony Blinken: "We meet at an inflection... |
| ... |
 The News And Times The News And Times | 21h | |
|
|
|
| Russia can't meet India arms deliveries due to Ukraine war, Indian ... - Egypt Independent |
| Russia can't meet India arms deliveries due to Ukraine war, Indian ... Egypt Independent |
 "Russia-Ukraine war" - Google News "Russia-Ukraine war" - Google News | 22h | |
|
|
|
| Crime and Criminology from Michael_Novakhov (10 sites): "political crimes"... |
| War crimes: 20 after Iraq, George W. Bush deserves charges Tacoma News Tribune "political crimes"... |
 Global Security News from Michael_Novakhov (30 sites) Global Security News from Michael_Novakhov (30 sites) | 22h | |
|
|
|
| Latest on global markets and banking crisis: Live updates - CNN |
| Latest on global markets and banking crisis: Live updates CNN |
 "global threats to U.S. security 2023" - Google News "global threats to U.S. security 2023" - Google News | 22h | |
|
|
|
| Erdogan urges end to Ukraine war in call with Russia's Putin - TRT World |
| Erdogan urges end to Ukraine war in call with Russia's Putin TRT World |
 "Russia-Ukraine war" - Google News "Russia-Ukraine war" - Google News | 22h | |
|
|
|
| Russia 'largely stalled' in Bakhmut, shifting focus, UK says - The Associated Press |
| Russia 'largely stalled' in Bakhmut, shifting focus, UK says The Associated Press |
 "russia-ukraine war" - Google News "russia-ukraine war" - Google News | 22h | |
|
|
|
| Rwanda frees Paul Rusesabagina of 'Hotel Rwanda' fame - WAPT Jackson |
| Rwanda frees Paul Rusesabagina of 'Hotel Rwanda' fame WAPT Jackson |
 "National security adviser Jake Sullivan" - Google News "National security adviser Jake Sullivan" - Google News | 22h | |
|
|
|
 | 1. World from Michael_Novakhov (27 sites): CNN.com - RSS Channel - World: A threat... |
| For months hundreds of thousands of Israelis have been taking to the streets across the country to regularly... |
 Global Security News from Michael_Novakhov (30 sites) Global Security News from Michael_Novakhov (30 sites) | 22h | |
|
|
|
 | 1. World from Michael_Novakhov (27 sites): Latest & Breaking News on Fox News: Jane... |
| Jane Fonda said on Friday that Jennifer Lopez "never apologized" for cutting her eyebrow during a slapping... |
 Global Security News from Michael_Novakhov (30 sites) Global Security News from Michael_Novakhov (30 sites) | 22h | |
|
|
|
 | 1. World from Michael_Novakhov (27 sites): Latest & Breaking News on Fox News: Johnny... |
| Johnny Depp is enjoying his peaceful environment in Somerset, England. The "Pirates of the Caribbean"... |
 Global Security News from Michael_Novakhov (30 sites) Global Security News from Michael_Novakhov (30 sites) | 22h | |
|
|
|
 | 1. World from Michael_Novakhov (27 sites): Latest & Breaking News on Fox News: What's... |
| What makes a good marriage? That's the question I popped at a small dinner gathering not long ago. Looking... |
 Global Security News from Michael_Novakhov (30 sites) Global Security News from Michael_Novakhov (30 sites) | 22h | |
|
|
|
| 1. World from Michael_Novakhov (27 sites): Latest & Breaking News on Fox News: The... |
| An emerging superbug is once again making headlines, but this time, it is a fungus raising the alarm.... |
 Global Security News from Michael_Novakhov (30 sites) Global Security News from Michael_Novakhov (30 sites) | 22h | |
|
|
|
| Two migrants found dead on train east of Uvalde - WFAA.com |
| Two migrants found dead on train east of Uvalde WFAA.com |
 "Uvalde" - Google News "Uvalde" - Google News | 23h | |
|
|
|
| "global security" - Google News: Pursuing Peace Through Partnerships, Local... |
| Pursuing Peace Through Partnerships, Local Engagement, and ... Department of State "global security"... |
 1. US Security from Michael_Novakhov (87 sites) 1. US Security from Michael_Novakhov (87 sites) | 23h | |
|
|
|
| |
| Russian military command will need to commit a significant number of forces to the frontline to either... |
 ISW (Twitter) ISW (Twitter) | 23h | |
|
|
|
| Vice President Harris embarks on history-making Africa trip amid US-China competition... |
| Vice President Harris embarks on history-making Africa trip amid US-China competition CNN |
 "National Security Council" - Google News "National Security Council" - Google News | 23h | |
|
|
|
| Uvalde, TX Mayor Don McLaughlin sounds off on border crisis: 'How many lives have... |
| Uvalde, TX Mayor Don McLaughlin sounds off on border crisis: 'How many lives have to be lost?' Fox News |
 "Uvalde" - Google News "Uvalde" - Google News | 23h | |
|
|
|
| Two dead as migrants found 'suffocating' in train after call to Texas police - East... |
| Two dead as migrants found 'suffocating' in train after call to Texas police East Anglian Daily Times |
 "Uvalde" - Google News "Uvalde" - Google News | 23h | |
|
|
|
| U.S. Special Forces Want to Use Deepfakes for Psy-Ops - The Intercept |
| U.S. Special Forces Want to Use Deepfakes for Psy-Ops The Intercept |
 "global threats to U.S. security 2023" - Google News "global threats to U.S. security 2023" - Google News | 23h | |
|
|
|
| Vice President Harris embarks on history making Africa trip amid US ... - CNN |
| Vice President Harris embarks on history making Africa trip amid US ... CNN |
 "National Security Council" - Google News "National Security Council" - Google News | 1d | |
Comments
Post a Comment